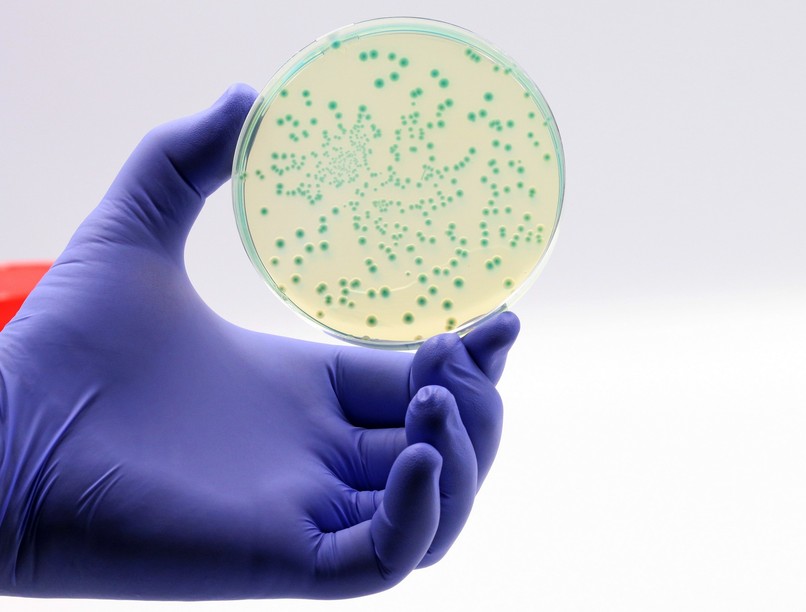
spanyolország szuperbaktérium halál

Spanyolországban nyolcszor többen haltak meg az antibiotikumoknak ellenálló, úgynevezett szuperbaktériumok okozta fertőzés miatt 2023-ban, mint azt a szakemberek eddig gondolták a rendelkezésre álló adatok alapján.
A spanyol Klinikai Mikrobiológiai és Fertőző Betegségek Társasága (SEIMC) által, 130 egészségügyi intézmény bevonásával készített vizsgálat szerint 2023-ban 170 ezer beteget diagnosztizáltak multirezisztens baktériumfertőzéssel, akik közül 24 ezren 30 napon belül életüket vesztették.
A spanyol egészségügyi minisztérium legutóbbi, még 2015-ben kiadott jelentésében évi 3 ezerre becsülte a szuperbaktériumok okozta halálozást, míg az Európai Betegségmegelőzési és Járványvédelmi Központ (ECDC) mintegy kétezerre, az Egészségügyi Világszervezet (WHO) európai regionális irodája több mint hatezerre tette a halálozást 2019-ben.
Dr. Rafael Cantón, a SEIMC szóvivője és a kutatás egyik szerzője szerint az eredmények közötti jelentős eltérések a különböző vizsgálati módszerekkel magyarázhatók, mert az elérhető hazai és nemzetközi tanulmányok elsősorban szakirodalmi áttekintésen és becsléseken alapultak.
A most közzétett kutatás különlegessége, hogy 300 mikrobiológus és infektológus szakember három különböző évben, 2018-ban 2019-ben és 2023-ban, multirezisztens baktériumok okozta fertőzéssel diagnosztizált páciensek állapotának alakulását követte 30 napig, hogy pontosabb képet kapjanak a szuperbaktériumok okozta probléma nagyságáról - tette hozzá.
Megállapításuk szerint az első évben 155 ezren fertőződtek meg szuperbaktériummal, közülük 20 ezren vesztették életüket, a második évben 210 ezer betegből 18 ezer hunyt el.
A legtöbb, az esetek 42,7 százalékát jelentő megbetegedés húgyúti fertőzés volt, de a legtöbb halálos áldozat tüdőgyulladás miatt vesztette életét - részletezte.
A kutató felhívta a figyelmet arra, hogy az antibiotikum-rezisztencia kialakulásához nagyban hozzájárul az antibiotikumok helytelen és túlzott használata, amely egyre ellenállóbbá teszi a baktériumokat a meglévő kezelésekkel szemben.
A szakemberek szerint fennáll a veszélye, hogy 2050-re az első számú halálozási okot a rezisztens fertőzések jelentik majd.

Legyőzhetők a szuperbaktériumok? Magyar kutatók új felfedezése!
Kövesse az Egészségkalauz cikkeit a Google Hírek-ben, a Facebook-on, az Instagramon vagy a X-en,Tiktok-on is!